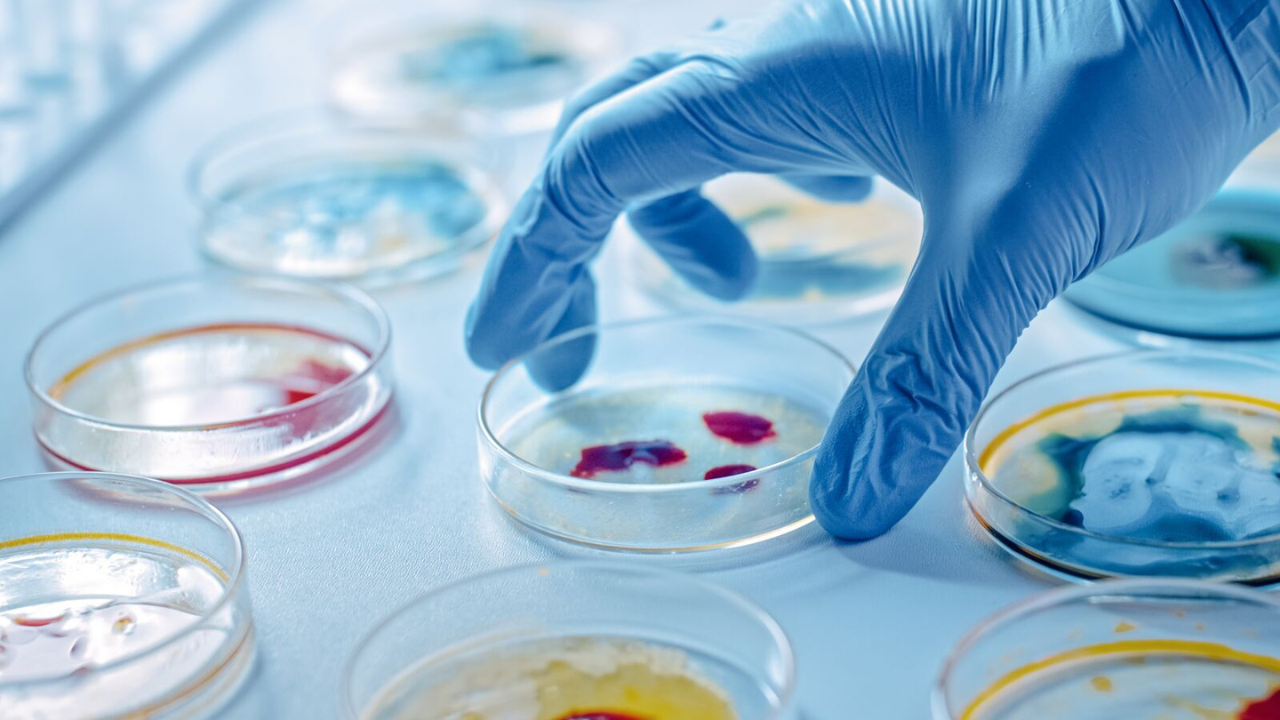

Diagnostic Services
At AI MEDISCOPE, we are committed to delivering highly accurate and reliable diagnostic results through advanced fully automated laboratory systems. Our diagnostic services cover a wide range of pathology investigations that help doctors detect, monitor, and manage various health conditions effectively. Using modern technology, strict quality control protocols, and trained laboratory professionals, we ensure that every test result is precise and dependable. Our goal is to provide the people of Raidighi and surrounding areas access to high-quality diagnostic facilities without needing to travel to distant cities. From routine blood tests to specialized investigations, AI MEDISCOPE offers comprehensive pathology services designed to support better medical decisions and improved patient care.

Hematology
Hematology is the branch of pathology that focuses on the study of blood and blood-related disorders. At AI MEDISCOPE, our hematology laboratory is equipped with fully automated analyzers that provide accurate and rapid analysis of blood samples. We conduct a wide range of hematological tests including Complete Blood Count (CBC), hemoglobin levels, platelet count, and other blood-related investigations. These tests play a crucial role in detecting conditions such as anemia, infections, blood disorders, clotting abnormalities, and certain chronic diseases. Our advanced technology ensures precise measurement and consistent results, while our quality control procedures maintain high diagnostic standards. Hematology tests are often the first step in understanding a patient’s overall health status. At AI MEDISCOPE, we ensure reliable blood analysis that supports doctors in diagnosing conditions early and planning the most appropriate treatment for patients.

Biochemistry
Clinical biochemistry involves the analysis of chemical substances present in blood and other body fluids to assess the functioning of vital organs and metabolic processes. At AI MEDISCOPE, our fully automated biochemistry analyzers provide highly accurate testing for a wide range of parameters. These include blood glucose levels, liver function tests, kidney function tests, lipid profiles, thyroid profiles, and many other essential biochemical investigations. These tests are extremely important in diagnosing and monitoring conditions such as diabetes, liver diseases, kidney disorders, hormonal imbalances, and cardiovascular risks. By using modern automated systems, we ensure quick processing of samples with minimal human error. Our laboratory follows strict quality assurance protocols to maintain the highest level of reliability in test results. Through our comprehensive biochemistry services, AI MEDISCOPE supports physicians in making informed medical decisions for effective patient care.

Immunology
Immunology testing plays an important role in understanding how the body’s immune system functions and how it responds to infections, diseases, and hormonal changes. At AI MEDISCOPE, we offer advanced immunology testing using modern automated technology to ensure precise and dependable results. These tests include hormone assays, thyroid-related investigations, and other specialized tests that help diagnose immune system disorders, endocrine conditions, and various chronic diseases. Immunology investigations are essential for identifying conditions such as autoimmune diseases, hormonal imbalances, fertility-related issues, and certain infectious diseases. Our automated laboratory equipment allows us to process samples efficiently while maintaining high accuracy and consistency. Each test is conducted following strict quality control standards to ensure reliable diagnostic outcomes. At AI MEDISCOPE, our immunology services help doctors better understand complex health conditions and guide them in providing appropriate treatment and medical care.
Microbiology
Microbiology focuses on the detection and identification of microorganisms such as bacteria, viruses, fungi, and parasites that cause infections in the human body. At AI MEDISCOPE, our microbiology laboratory is designed to accurately analyze samples and identify infectious agents responsible for various diseases. We perform different microbiological investigations that help diagnose bacterial infections, urinary tract infections, respiratory infections, and other microbial diseases. Through careful laboratory techniques and proper sample handling, we ensure precise identification of pathogens that may affect patient health. Microbiology testing is extremely important in guiding doctors to prescribe the correct treatment, including appropriate antibiotics or medications. Our laboratory follows standardized procedures and quality control measures to maintain reliability in every test performed. With accurate microbiological analysis, AI MEDISCOPE supports early detection of infections and helps doctors manage diseases effectively for better patient outcomes.

Clinical Pathology
Clinical Pathology is a vital branch of laboratory medicine that focuses on the examination and analysis of body fluids such as blood, urine, and other specimens to diagnose and monitor various health conditions. At AI MEDISCOPE, our Clinical Pathology department is equipped with modern automated systems that help ensure accurate and reliable test results. These tests assist doctors in detecting infections, metabolic disorders, organ dysfunction, and other medical conditions at an early stage.
Your health deserves precision and care.
Visit AI MEDISCOPE today for trusted diagnostics and expert consultation.
- Raidighi, South 24 Parganas, West Bengal – 743383 (Near Raidighi Rural Hospital)
- 9147729861
- query@aimediscope.in
